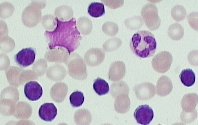

A 72 y/o man with hx of chronic alcoholism and smoking presents to your office with extreme fatigue. Denies any fever or weightloss or nightsweats. Vital signs were normal and physical examination reveals generalized small lymphadenopathy and mild splenomegaly. Laboratory studies reveal CBC with hgb 9.5, wbc 10k with 25% neutrophils, 65% mature lymphocytes and 9% monocytes, platelets 90k. LDH is increased at 600 and reticulocyte count of 8.0% . Haptoglobin level is 22mg% ( N 27 to 160) and urinary hemosiderin level is with in normal limits. Basic metabolic panel, Vitmain B12 and Folic acid levels are within normal limits. Peripheral smear is shown below and reveals many Smudge cells.
Most likely etiology of this patient’s Anemia is :
A. Microangiopathic Hemolysis
B. Bone marrow infiltration with Chronic Lymphocytic Leukemia
C. Acute Lymphoblastic Leukemia
D. Autoimmune Hemolysis
E. Hypersplenism
Copy Rights: USMLEGalaxy
Filed under: Uncategorized |

B. bad prognosis with anemia and thrombocytopenia
b
D—pt has CLL, and good reticulocytes response, indicating marrow is function. likely cause of anemia–autoimmune destruction
D is the answer,Increased reticulocyte count and increased LDH goes with hemolysis. The peripheral smear does not show schistocytes which rules out MAHA.
Smear is here https://usmlegalaxy.files.wordpress.com/2010/07/cells.jpg
All it shows is smudge cells consistent with CLL. Absence of hemosiderin rules out Intravascular hemolysis. Only thing left is autoimmune hemolysis and this is autoimmune hemolysis by exclusioneven though question does not comment on Direct coomb test.
I think this Q is asked because in CLL, anemia is an indication for treating CLL. And anemia can be of two causes
a) Bone marrow infiltration with CLL
b) Autoimmune hemolysis
We should know the difference b/w the two because if anemia is present in CLL due to BM infiltration, CLL has to be treated with chemotherapy. But if anemia in CLL is because of autoimmune hemolysis, steroids are the treatment not chemotherapy ( Reference : Dr.Red Hematology)
DDDDDDDDDDDDDDDDDDDDDDDDDDDDDDDDDDDDDDDDDDDDDDDDDDDDDDDDDDDDDDDDDDDDDDDDDDDDDDDDDDDDDDDD
DDDDDDDDDDDDDDDDDDDDDDDDDDDDDDDDDDDDDDDDDDDDDDDDDDDDDDDDDDDDDDDDDDDDDDDDDDDDDDDDDDDDDDDDD